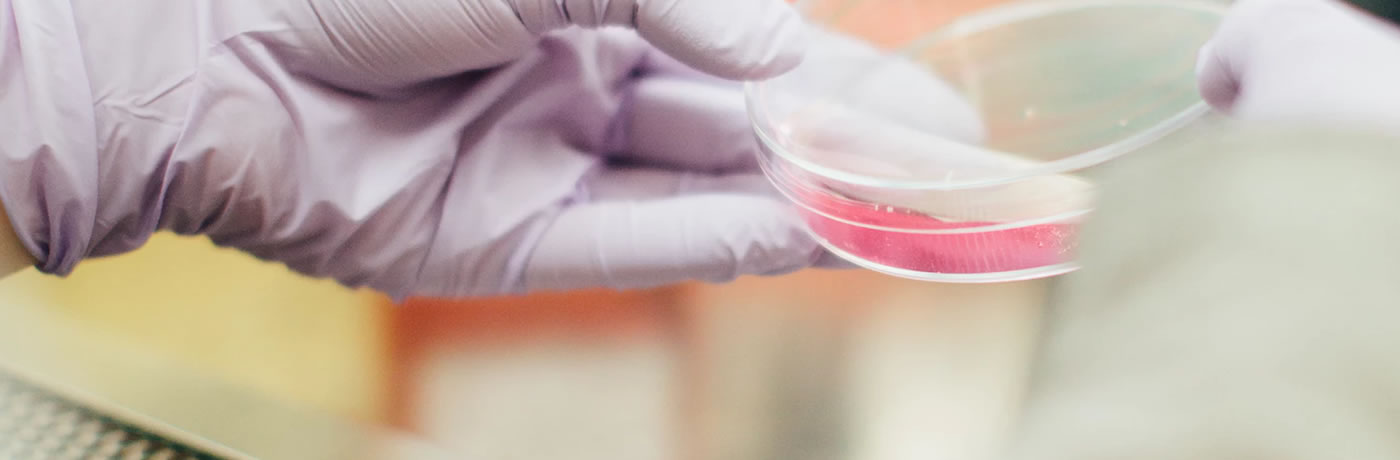

About the Company
CHIMEC GmbH is the subsidiary of Italian CHIMEC SPA, which was established in 1971 and is based in Rome, Italy. It operates in more than 65 countries directly or through subsidiaries.
CHIMEC specializes in the development and application of power chemicals and technologies for the E & P industry, refineries and the petrochemical industry as well as other industrial sectors (metal processing, pharmaceuticals, etc.).
The production comprises five main business sectors: oilfields, processes, fuel additives, water and decontamination.
The additions, technologies and consulting services are aimed at optimizing processes, maximizing profits and reducing environmental impacts.
For more information about Chimec GmbH please visit chimec.com.
The Challenge
The growing complexity of the IT environment has required a new solution that had to meet the following goals:
Cost savings
Failure safety
Easier administration
Centralized backups
Live Migration
The ERP software, Active Directory servers, application servers, mail servers, data servers and the VOIP telephone system had to be kept virtualized and highly available. Even with a total failure of one of the virtualization servers the operation had to be maintained.
In addition, reliable backups must be performed daily on a backup server.
The Solution
CHIMEC GmbH now uses 60% less hardware and all existing servers run faster and more reliably than ever before.
All physical servers were moved to eEVOS (euroNAS Enterprise Virtualization OS). The existing Windows and Linux servers were migrated and virtualised using euroNAS Support. Since then, they have been stable and redundant.
Hardware is based on Supermicro Twin Servers, which are mirrored directly via a dedicated 10 Gigabit network connection and thus ensure the highest possible failure safety and redundancy.
The daily backups are performed with eEVOS VM Backup on an HP Proliant server running euroNAS Premium Ultra storage OS.